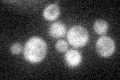
YDR247W
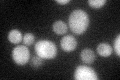
YDR247W

View description
Cytoplasmic serine/threonine protein kinase; identified as a high-copy suppressor of the synthetic lethality of a sis2 sit4 double mutant, suggesting a role in G1/S phase progression; homolog of Sks1p
Localization:
Intensity:
Fold change:
Significance:
-
C’ GFP library in SD
cytosol31.87 -
N' NOP1pr-GFP in SD

cytosol22.1895 -
N' TEF2pr-mCherry in SD

cytosol93.3056 -
N' NATIVEpr-GFP in SD

below threshold20.9089 -
N' TEF2pr-VC and Cyto-VN in SD

below threshold23.113 -
C’ GFP library in SD+DTT
cytosol31.020.97No -
C’ GFP library in SD+H2O2

cytosol26.570.83No -
C’ GFP library in Starvation Media

cytosol15.990.5No -
C’ GFP library on the background of Pup2-DaMP

cytosol -
C’ GFP library on the background of CCT mutant

cytosol31.27380.980941No
